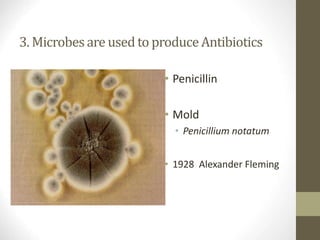
3. Microbesare usedto produceAntibiotics
• Penicillin
• Mold
• Penicillium notatum
• 1928 Alexander Fleming

This document provides an overview of microbiology and microorganisms. It defines microbiology as the study of microorganisms that are too small to be seen with the naked eye. It discusses the six kingdoms of life and highlights bacteria, protozoa, fungi and viruses as microorganisms studied in microbiology. The document also summarizes Koch's postulates for establishing causation between microbes and disease.